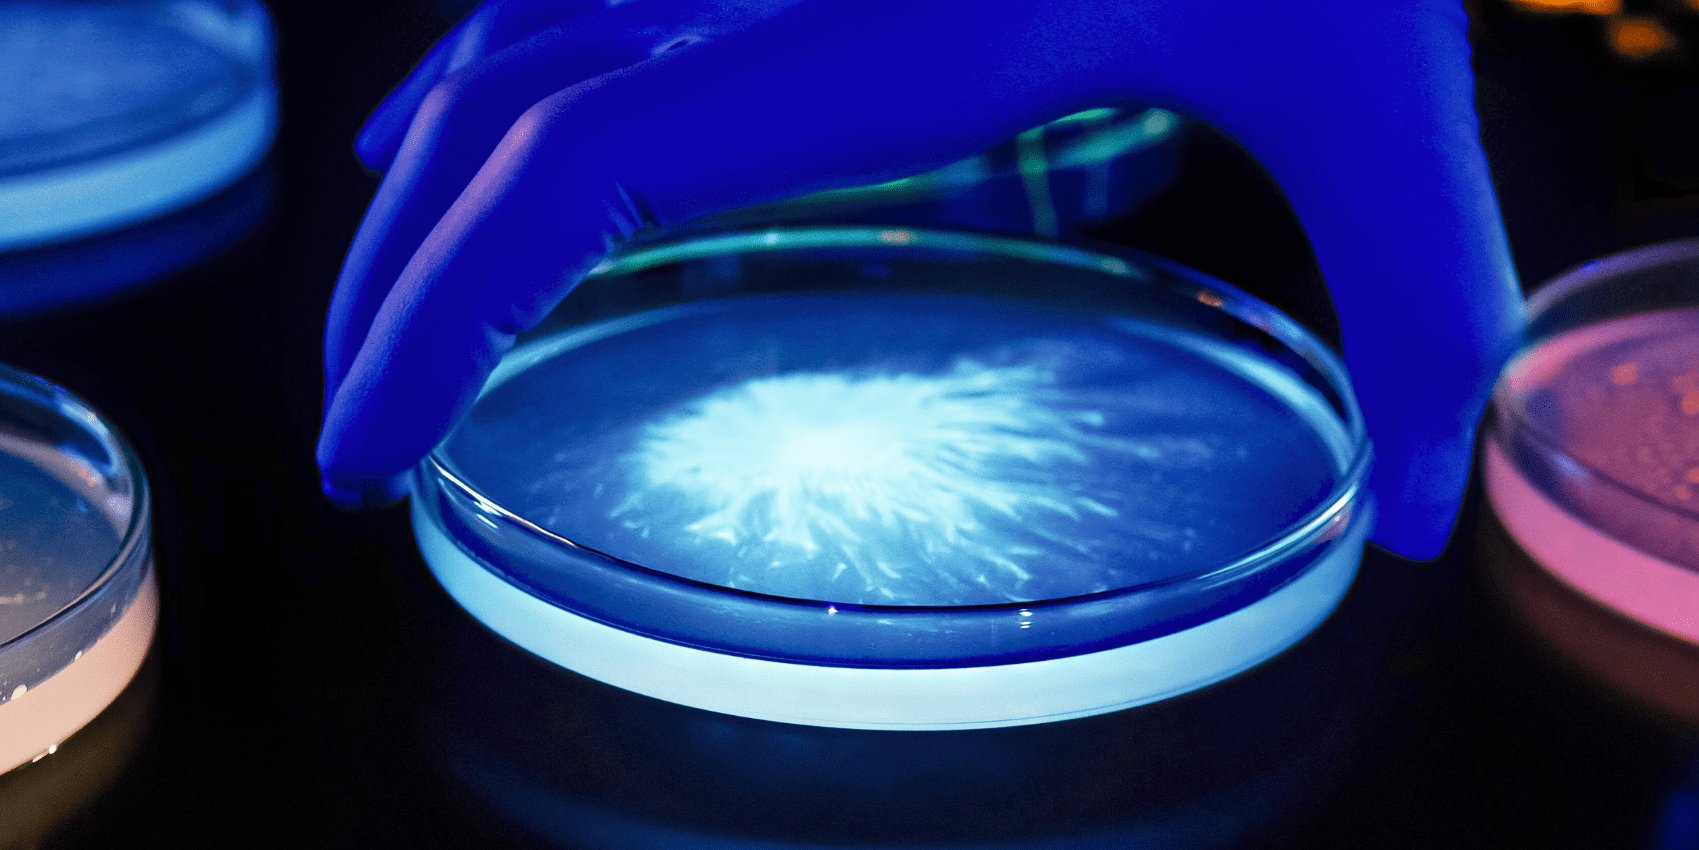
Science Pic 2

Beauty is a science story
The beauty industry: An avant-garde mindset
Progress is inextricably tied to the quest for beauty. Born with the development of modern science and technology in the 19th and 20th centuries, the beauty industry continues to cultivate an avant-garde mindset today. To remain competitive, companies strive to constantly innovate, offer unique products and respond to changing consumer demand. Each year, the European beauty industry spends €2.35bn on research and innovation (1). This includes the development of new formulations, the incorporation of innovative ingredients and the introduction of cutting-edge technologies such as smart devices and Apps to offer personalized experiences to consumers. Around 30,000 scientists contribute to the industry in Europe, with 77 scientific innovation facilities (2). 25% to 30% of the 10,000 cosmetic products of large companies in Europe are reformulated every year, showcasing the dynamism of the industry (3).
(1) Cosmetics Europe, 2021.
(2) Cosmetics Europe, 2022.
(3) Cosmetics Europe, 2021.

L’Oréal Groupe: creating a global innovation ecosystem
L’Oréal draws on a cutting-edge biotech innovation ecosystem to enhance the scientific expertise of researchers at 20 research centres around the globe. Through its venture capital fund BOLD, the Group makes minority investments in innovative startups. Innovation has always been an important part of L’Oréal’s DNA. Now more than ever science and innovation drive our Group, with an investment of over €1.28 billion in 2023 alone. L’Oréal’s innovation pipeline is fuelled by 20 research centres in 11 countries. The Research & Innovation team, made up of more than 4,200 scientists and 8,000 digital, tech and data specialists, work to invent the future of beauty, with more than 610 patents filed in 2023– 54% by female inventors. Around 3,400 new formulas launched in 2023.
Inclusivity at the heart of our R&I
In 2030, 40% of humanity will have curly hair due to the mixing of populations. For years, women have been straightening their hair to fit a beauty archetype. Embracing their curls is now essential to express their personality. Keen insight into the world’s many different skin and hair types lies at the heart of L’Oréal’s Research and Innovation strategy. This cutting-edge scientific awareness allows us to create and market products tailored to meet specific biological or cultural needs, catering to the infinite diversity of consumer aspirations.

An unprecedented study on skin and hair
“My Skin & Hair Journey” is the name of a multi-year study launched by L’Oréal and Verily, an Alphabet company and a global leader in precision health technologies. The longitudinal study covers the largest-ever beauty cohort and aims to understand the biological, clinical and environmental factors that contribute to skin and hair health throughout life.
The initiative is an unprecedented milestone in the Group’s research into longevity and the exposome. It involves thousands of American women aged 18 to 70 from diverse backgrounds and with various skin and hair types. By collecting new data on perceptions and experiences related to skin and hair health, the study will analyse the individual impact of different lifestyle, environment, wellbeing and beauty routines. The resulting insights will enable L’Oréal to further push the boundaries of innovation to create highly personalized beauty routines.
The research driving high-performance formulas
Research & Innovation teams have made it their mission to enhance performance by creating formulas that meet the highest standards of safety, efficacy, experience and sustainability. In 2023, La Roche-Posay launched RegenMedic, a premium franchise for North Asia, combining ProXylane and Niacinamide. The reparative, anti-ageing formula stimulates the skin’s natural regeneration process and is suitable for use after non-invasive cosmetic procedures or as part of a daily routine. Another innovation, Garnier Good, offers a new generation of at-home permanent hair color solutions using hybrid technology with 90% natural-origin ingredients and 10% synthetic active ingredients for outstanding color performance.
Melasyl, a revolutionary active ingredient to target hyperpigmentation
Pigmentation disorders affect a significant portion of the global population, regardless of natural skin color. L’Oréal conducted over 121 clinical studies in 13 countries across five continents with more than 12,000 participants to understand the pigmentation process. A recent AI-based study involving over 600,000 women highlighted age-related differences in the development of localized hyperpigmentation. L’Oréal built on this unique expertise in skin pigmentation to develop Melasyl, a patented active ingredient able to keep localized hyperpigmentation in check, and the first molecule to act on localized excess melanin precursors before they transform into colored pigmentation. This innovative solution is protected by more than 20 patents.

Haircare: at the forefront of scientific advances
Companies are also investing in research and innovation to stay at the forefront of scientific advances in haircare. In fact, UV exposure, climate (temperature, humidity), air pollution, water quality, chemical, physical and mechanical factors, all have a significant impact on the health of people’s hair. Innovation in the haircare industry also extends to sustainability and environmental awareness. Many companies are focusing on developing ecological and sustainable solutions, such as packaging made from recycled materials, reducing water consumption in product manufacturing and using renewable energy sources to reduce the industry’s ecological footprint.
Beauty: powered by green sciences
Green Sciences are the scientific disciplines, from cultivation and biotechnology to green chemistry and sciences of formulation that we are harnessing to meet our sustainability goals while offering you safe and effective products.
They are opening up unprecedented new fields of exploration to unlock nature’s many remaining secrets, to enabling us to step back from petrochemicals.
Through new discoveries powered by green sciences and tech, L’Oréal’s Research & Innovation seizes every opportunity to help the Group achieve its goal of ensuring that 95% of its ingredients in formulas are biobased, derived from abundant minerals or from circular processes by 2030. This figure is already at 65% has already been achieved by the Group in 2022.
Cognitive science: new frontiers
Cognitive sciences reveal new fields of innovation that can contribute to the well-being of people and the planet. L’Oréal has opened four cognitive science laboratories around the world to explore this new scientific territory, to create disruptive beauty experiences that highlight the power of emotions, multisensory perception, memory and behavior.

1.2Bn
invested in Research & Innovation in 2023
+4,000
scientists worldwide
20
research centers in 11 countries
Science & tech for good
Sustainability: L’Oréal for the Future
In the context of growing environmental and social challenges, L’Oréal has accelerated its transformation towards a model respecting planetary boundaries and reinforcing its commitments to both sustainability and inclusion. Launched in 2020, the L’Oréal for the Future program embodies the Group’s CSR ambitions and its conviction that companies have a concrete role to play in taking up the challenges of our time.
The program pursues a strategy built on three key pillars: transforming the Group’s business to reduce our impact on the climate, water, biodiversity and resources; engaging stakeholders; and actively addressing today’s most urgent social and environmental issues.
Actions include providing support for highly vulnerable women and people most exposed to climate change-driven disasters while investing in ecosystem regeneration and the circular economy. With more than €200 million of total investments committed, L’Oréal is addressing social and environmental needs by helping build resilience for people and the planet (4).
(4) Source: Annual report 2023.
Biotechnology: at the heart of our innovation
The multidisciplinary field of biotechnology combines insights and methods from biology, chemistry, tech and engineering for innovation inspired by living organisms, their biological know-how and various components. For L’Oréal, this paves the way for sustainable alternatives to certain ingredients by drawing on a nature-inspired approach and developing new materials with unmatched performance. Research & Innovation teams are harnessing the power of biotech to explore a new realm of science, delivering active ingredients with groundbreaking cosmetic properties that combine high performance with reduced environmental impact.
Using biology to improve safety
L’Oréal has pioneered engineered tissue through its EpiSkin subsidiary for 40 years and committed to animal-free testing methods 14 years before such practices were required by regulations. We promote the use of reconstructed human tissue to test the reliability and safety of ingredients used in cosmetics. The latest advances were showcased at the 12th World Congress on Alternatives to Animal Testing in Life Sciences, which highlighted our EpiSkin Academy education program.
L’Oréal joined the ICCS and AFSA to promote alternative methods across the beauty industry, which includes creating masterclasses on the issue. In 2023, we also partnered with Bakar Labs, a biotech incubator at the University of Berkeley in the United States, offering new opportunities to startups in the ecosystem and providing free access to L’Oréal’s 3D reconstructed skin models.
+100
quality controls for each cosmetic product
100%
of L’Oréal’s plastic packaging will be refillable, reusable, recyclable or compostable by 2030
Science and the importance of senses
Stronger together
Why is esthetic emotion a constant throughout the history of humanity? Unlike other species, humans are born without claws, teeth or even hair. According to scientific studies, our vulnerability at birth, naked and exposed, means that the survival of our species depends on the social bonds we form. There is an adaptive biological function of esthetics. By creating the social phenomenon of attention-attract, beauty draws us to others. In evolutionary terms, this attraction plays a positive role. The increasing size of human groups and the growing number of cultural competencies maintained and passed on to future generations are crucial contributions to the developmental success of Homo sapiens. esthetic emotion has become an integral part of our biological heritage because it has likely helped humanity to survive. In short, it binds us together.
The magic touch: our skin contains five million sensory cells
Our skin is the barrier between our bodies and the outside world. It envelops, contains and protects us, but also connects us directly with the external environment. By caring for our skin, we tend to our psychological, emotional and social well-being. The skin is the largest organ in the human body (ca. 2 m2) and contains five million sensory cells. It is essentially a giant sensory receptor, with the highest concentration of receptors found on our fingertips, making this the most sensitive part of our bodies. There is a strong link between our skin and our brains because they both derive from the same embryonic tissue.

Our skin cells produce feelings of pleasure, desire and seduction
Every day of our lives, the quest for beauty opens the path of desire. Since the democratization of the mirror in the 18th century through to the many avatars on social media today, self-image has played a pivotal role in our lives. According to recent studies, an esthetic experience can hit you in just a fifth of a second. During this time, your brain activity is modified, and neurochemicals are released that produce feelings of pleasure.Many psychiatric studies have shown that new-borns derive their sense of safety, attachment and self from physical contact with their mothers. Throughout our lives, our skin reflects the ups and downs of our existence. It has its own language, which can reveal much about your physical and mental health. Touch is a vitally important sense.Through the laws of attraction, beauty works like a social glue. Emotional touch triggers a cascade of mood enhancing and pain-reducing hormones (e.g., oxytocin, endorphins etc.). Touch heightens feelings of gratitude, sympathy, trust and co-operation. Each sensation corresponds to a fundamental human message.Brain imaging studies have shown that the perception of beauty activates the same regions of the brain that are involved in cognitive processes such as decision making and attention. This suggests that the perception of beauty could have an influence on how people feel and behave.
Skincare : supporting dermatological research
L’Oréal Dermatological Beauty Pro is a digital community empowering health care professionals to improve their daily practice of dermatology through cutting-edge research, science and education on skin and haircare. More than 100,000 physicians have already joined the platform. L’Oréal supports dermatological research, scientific training by health professional, through hundreds of scientific articles, publications, expert interviews, educational videos and more…

The next frontier: unlocking the secrets of microbiome
L’Oréal funds a wide range of research projects, with a particular focus on unlocking the secrets of the microbiome - an invisible ecosystem of microorganisms that live on our skin. It helps our skin to heal naturally and contributes to its protective barrier. A balanced Microbiome is crucial for skin health. La Roche-Posay has conducted 33 studies on the role of the microbiome in atopic conditions, such as acne, rosacea and psoriasis. These studies looked at 1,500 patients and led to 16 scientific publications.
The science of fragrance
The powerful scent of our memories
Thanks for our 400 olfactory receptors, we can detect literally hundreds of billions of different smells! In our brains, our olfactory system is linked to a part of the brain known as the ‘limbic system’, which is responsible for our emotions. For that reason, our sense of smell is deeply intertwined with our emotions and memories and plays a crucial role in our relationships as well as our understanding of ourselves and the world. Smell is a sense of desire that raises our passions, sensuality and eroticism. Smells move us deeply and often unconsciously, enriching our lives and provoking indescribable feeling of joy.
Fragrances: the essence of innovation
The 21st century perfumer? AI is helping to develop unique, individual perfumes. For example, the YSL Scent-Station, presented in 2021, provides an unprecedented multisensory experience.
Launched by Yves Saint Laurent Beauté in 2022, in partnership with Emotiv, a leader in wireless EEG brain monitoring technology, this groundbreaking innovation records and analyzes consumers’ emotional responses to different fragrance families, then recommends the perfume that suits them best.
Among the L’Oréal Research & Innovation’s 3,900 experts, more than 60 scientists work in the fragrance laboratories, hand-in-hand with Fragrance Companies.
" The sense of smell, that mysterious aid to memory, had just received a whole world within him "
Victor HugoFrench novelist 19th Century